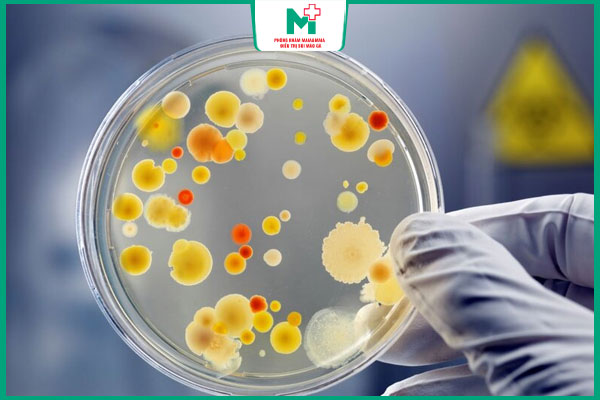

Lậu là một bệnh xã hội nguy hiểm, bởi vậy việc điều trị kịp thời và đúng cách rất quan trọng. Chữa bệnh lậu hết bao nhiêu tiền là câu hỏi được nhiều người quan tâm tìm hiểu. Thực tế chi phí thế nào? Cùng Phòng khám Maia&Maia tìm hiểu chi tiết qua bài viết dưới đây!
I. Chữa bệnh lậu hết bao nhiêu tiền?
Chi phí điều trị bệnh lậu hiện nay sẽ dao động từ khoảng 5.000.000 – 8.000.000 VNĐ trở lên. Tuy nhiên, con số cụ thể còn phụ thuộc vào tình trạng bệnh của từng người và phác đồ điều trị theo chỉ định từ bác sĩ. Người phát hiện bệnh sớm, chữa trị đúng phương pháp sẽ tiết kiệm được nhiều chi phí hơn so với trường hợp để bệnh chuyển biến nặng, có biến chứng.

II. Các yếu tố quyết định chi phí chữa lậu
Có rất nhiều yếu tố khác nhau quyết định tới chi phí điều trị bệnh lậu. Dưới đây là những yếu tố chính liên quan đến giá thành chữa lậu mọi người nên lưu ý:
1. Bệnh viện, phòng khám điều trị
Mỗi cơ sở điều trị bệnh lậu sẽ có mức giá riêng. Những cơ sở bệnh viện công thường có giá thấp hơn nhưng sẽ đông đúc. Ngược lại, phòng khám chuyên khoa uy tín với dịch vụ được cấp phép, trang thiết bị hiện đại, đội ngũ bác sĩ chuyên môn tốt thường có mức giá cao hơn nhưng đảm bảo dịch vụ nhanh chóng, tiện lợi và riêng tư hơn.
2. Chi phí thăm khám, xét nghiệm
Trước khi bắt đầu điều trị, bác sĩ cần thăm khám lâm sàng và thực hiện các xét nghiệm cần thiết để chẩn đoán chính xác tình trạng bệnh. Các xét nghiệm bệnh lậu phổ biến bao gồm xét nghiệm dịch niệu đạo (nam giới), dịch âm đạo (nữ giới), hoặc xét nghiệm máu, xét nghiệm nước tiểu. Chi phí cho các xét nghiệm này thường chiếm một phần nhỏ trong tổng chi phí điều trị.
3. Tình trạng hiện tại của bệnh
Đây là yếu tố quan trọng để quyết định chữa bệnh lậu hết bao nhiêu tiền. Cụ thể như sau:
- Giai đoạn đầu: Bệnh lậu ở giai đoạn cấp tính, mới khởi phát thường dễ điều trị hơn, chỉ cần sử dụng thuốc kháng sinh. Do đó, chi phí sẽ thấp hơn.
- Giai đoạn mãn tính: Nếu bệnh lậu đã chuyển sang giai đoạn mãn tính, vi khuẩn lậu đã kháng thuốc hoặc đã gây ra các biến chứng như viêm tinh hoàn, viêm buồng trứng, chi phí điều trị sẽ tăng lên đáng kể vì cần phác đồ phức tạp hơn và có thể phải can thiệp ngoại khoa.
4. Phương pháp điều trị lậu
Phương pháp điều trị bệnh lậu cũng là yếu tố quan trọng ảnh hưởng đến mức giá chữa bệnh, chi tiết như sau
- Thuốc kháng sinh: Đây là phương pháp phổ biến nhất cho bệnh lậu giai đoạn đầu. Bác sĩ sẽ kê đơn thuốc kháng sinh đường uống hoặc tiêm. Chi phí sẽ bao gồm tiền thuốc và chi phí thăm khám.
- Can thiệp ngoại khoa: Áp dụng cho các trường hợp bệnh đã có biến chứng hoặc vi khuẩn đã kháng thuốc. Phương pháp này có thể bao gồm kỹ thuật DHA (công nghệ nhiệt điện trường) để tiêu diệt vi khuẩn, hoặc phẫu thuật để xử lý các biến chứng như áp xe. Chi phí cho các thủ thuật này thường cao hơn nhiều so với dùng thuốc đơn thuần.

5. Chi phí tái khám kiểm tra
Sau khi kết thúc liệu trình điều trị ban đầu, bệnh nhân cần tái khám theo lịch hẹn của bác sĩ để đảm bảo vi khuẩn lậu đã được tiêu diệt hoàn toàn. Khoản chi phí này bao gồm chi phí thăm khám và các xét nghiệm kiểm tra lại, giúp xác định bệnh đã khỏi hẳn hay chưa.
III. Có nên lựa chọn chữa bệnh lậu giá rẻ?
Mọi người không nên vì muốn tiết kiệm chi phí mà lựa chọn những cơ sở chữa bệnh lậu có giá rẻ. Bởi chi phí điều trị thấp có thể đi kèm với những rủi ro sau:
- Chất lượng kém: Phòng khám không uy tín, sử dụng thuốc kém chất lượng hoặc trang thiết bị y tế lạc hậu, không đảm bảo hiệu quả điều trị.
- Nguy cơ tái phát cao: Điều trị không triệt để có thể khiến bệnh tái phát, thậm chí chuyển sang giai đoạn mãn tính, gây khó khăn và tốn kém hơn cho việc điều trị sau này.
- Biến chứng nguy hiểm: Bệnh không được chữa khỏi có thể gây ra nhiều biến chứng nghiêm trọng như vô sinh, viêm khớp, ảnh hưởng đến tim và hệ thần kinh.
Do đó, mọi người cần đặt hiệu quả điều trị và sức khỏe của bản thân lên hàng đầu. Để an toàn nhất, cần lựa chọn cơ sở y tế uy tín, có đội ngũ bác sĩ chuyên môn cao cùng trang thiết bị và cách điều trị hiện đại.

IV. Cách tiết kiệm chi phí khi chữa bệnh lậu
Nếu mọi người đang lo lắng về mức giá điều trị bệnh lậu thì dưới đây là một vài bí quyết hữu ích giúp tiết kiệm chi phí không nên bỏ qua:
- Đi khám và điều trị sớm ngay khi có triệu chứng.
- Chọn cơ sở y tế uy tín để tránh điều trị sai cách phải chữa lại nhiều lần.
- Tuân thủ đúng phác đồ của bác sĩ, không tự ý ngừng thuốc.
- Tái khám đúng hẹn để kiểm tra tình trạng và ngăn bệnh tái phát.
- Giữ lối sống lành mạnh, quan hệ an toàn để tránh lây nhiễm chéo.

Bài viết trên đây đã giải đáp cho mọi người vấn đề chữa bệnh lậu hết bao nhiêu tiền, cách tiết kiệm chi phí chữa bệnh lậu hiệu quả. Nếu có nhu cầu tư vấn thêm về các phương pháp điều trị bệnh lậu hiệu quả, an toàn liên hệ ngay với Phòng khám Maia&Maia qua hotline 032.845.1188.

